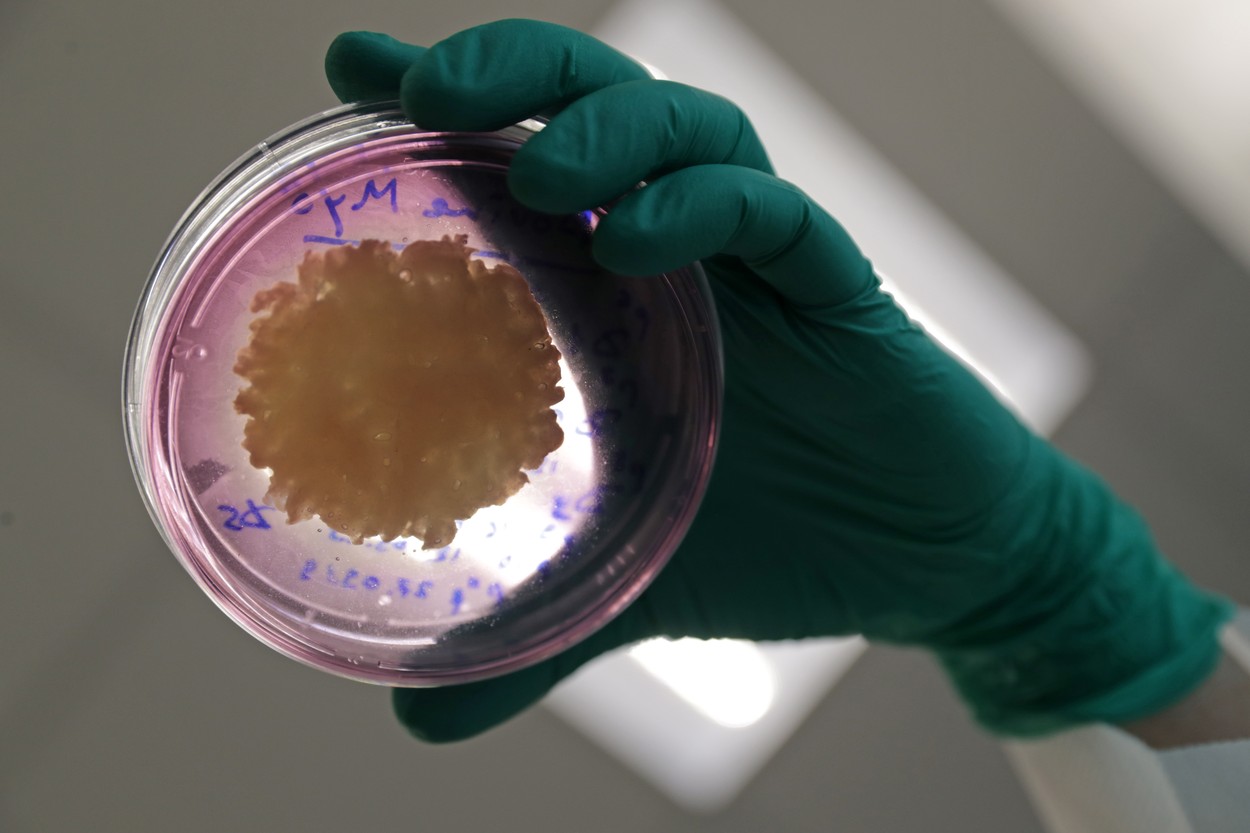
Carnea făcută în laborator ajunge, oficial, pe piață. Prima țară din lume care aprobă friptura din eprubetă

Carnea făcută în laborator ajunge, oficial, pe piață. Prima țară din lume care aprobă friptura din eprubetă
- Singapore a devenit prima țară din lume care aprobă friptura din eprubetă.
- Eat Just va vinde carne de pui crescută artificial.
- Carnea va fi oferită sub formă de nuggets.
Singapore a devenit prima țară din lume care aprobă friptura din eprubetă.
Statul asiatic permite start-up-ului american Eat Just să vândă carne de pui crescută artificial.
Trebuie să-ți spun că este carne adevărată, nu vreun substitut făcut din plante. Doar că nu provine din abator, ci din laborator. Totul începe de la câteva celule luate de la o găină, care sunt apoi crescute artificial.
Să mănânci carne adevărată, fără a vătăma planeta și animalele. Asta înseamnă carnea curată. Carnea va fi disponibilă întâi într-un restaurant din Singapore. Va fi oferită sub formă de nuggets.
Fondatorul Eat Just nu a spus cât va costa exact, ci doar că va avea un preț similar cu cel al cărnii de pui premium: „A fost o experiență foarte ciudată să stai la masă și să mănânci pui, dar în același timp puiul pe care îl mănânci să meargă pe lângă tine. Nu trebuie să mai provocăm moarte ca să producem mâncare.“
Anterior, start-up-ul american vindea un nugget cu 50 de dolari, din cauza costurilor mari de producție.